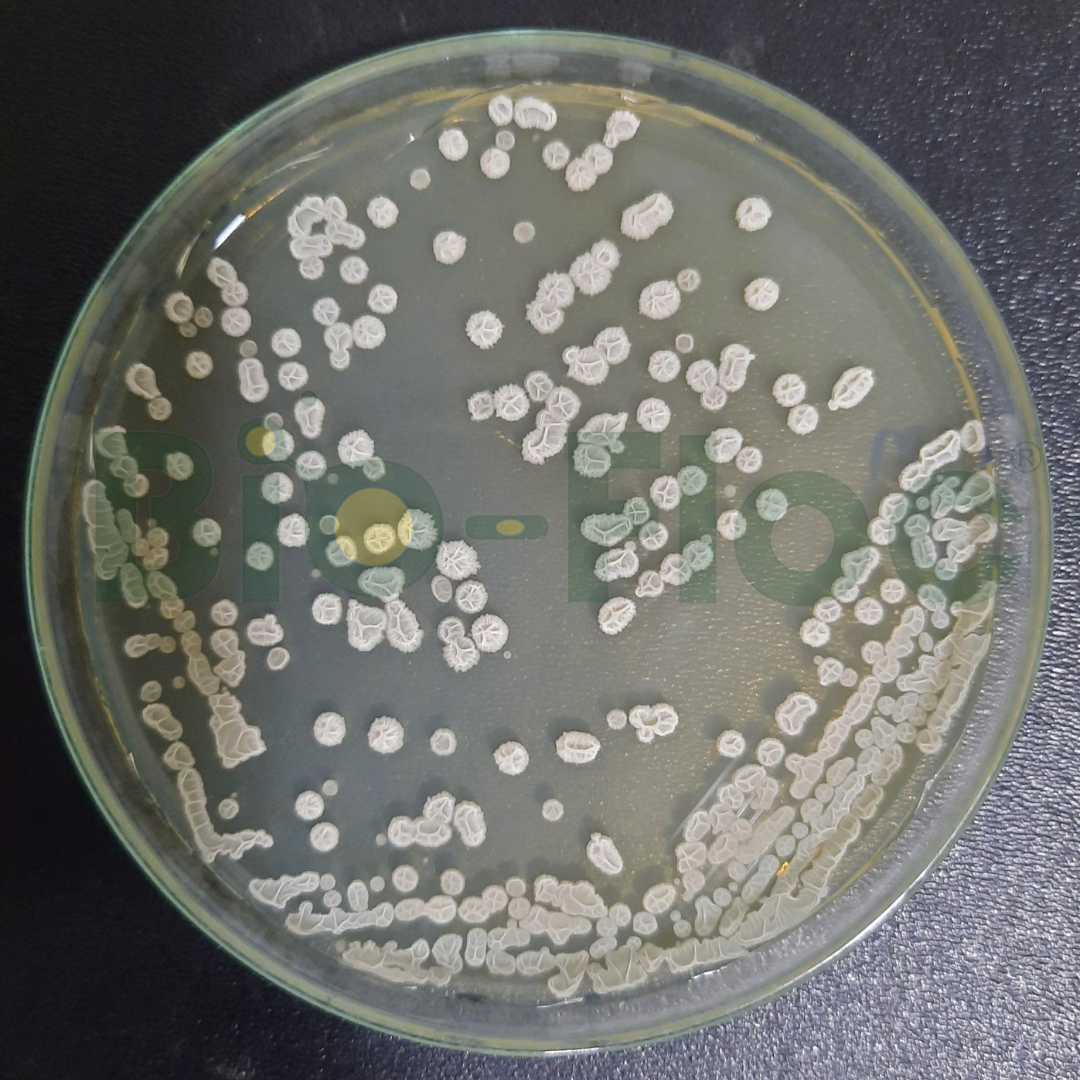
Vi khuẩn Bacillus
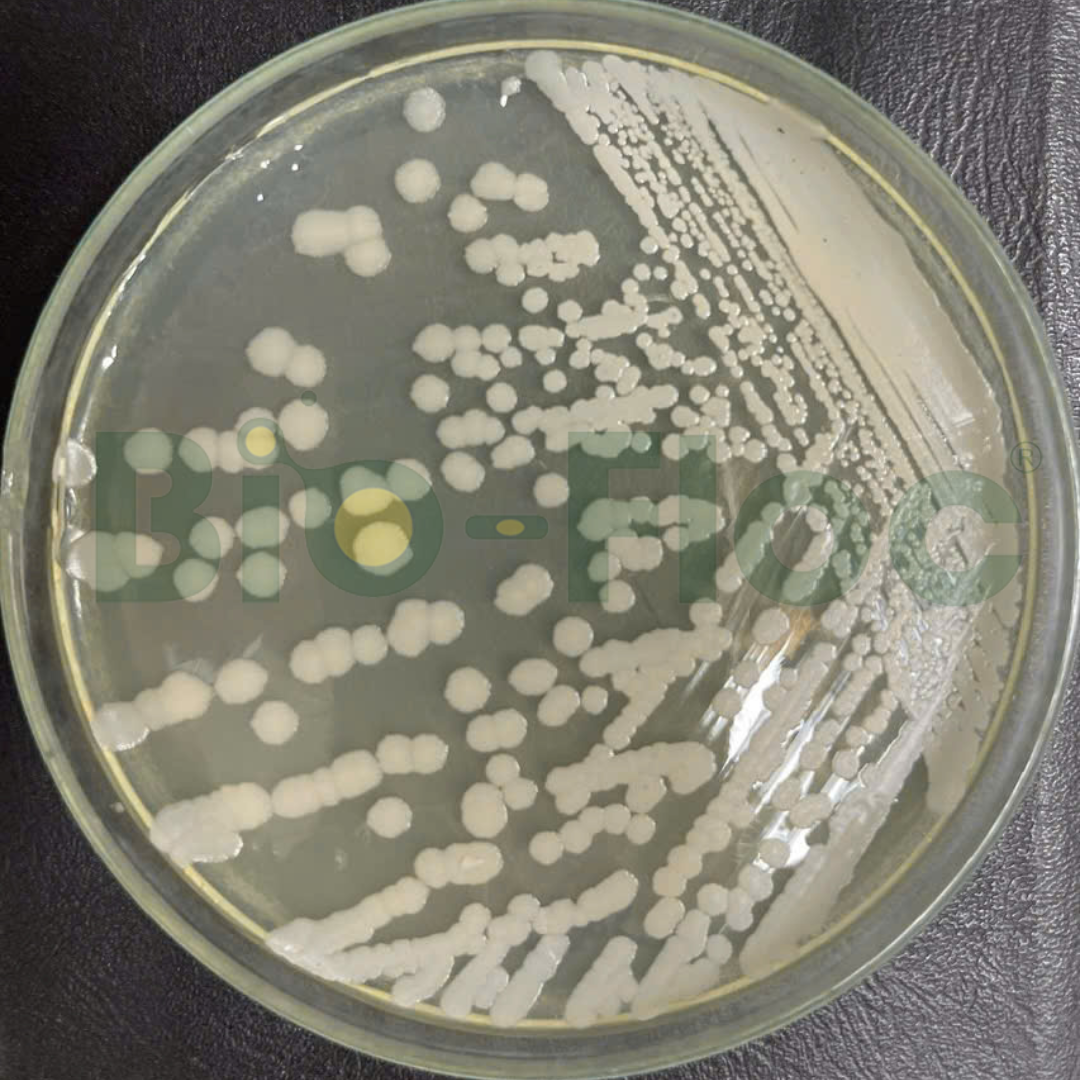
Vi khuẩn Bacillus

Với khả năng tạo bào tử bền vững, sinh enzyme mạnh và ức chế mầm bệnh tự nhiên, vi khuẩn Bacillus là một trong những dòng vi sinh vật có ích mạnh nhất, linh hoạt nhất và mang lại hiệu quả thực tiễn cao nhất trong thủy sản, trồng trọt và chăn nuôi.
Vậy Bacillus là gì, tại sao được xem là “trụ cột” trong ngành vi sinh nông nghiệp? Và vì sao doanh nghiệp cần lựa chọn chủng Bacillus thuần, ổn định khi phát triển sản phẩm?
Bio-Floc tổng hợp bài viết dưới đây để cung cấp góc nhìn đầy đủ và khoa học nhất.

Contents
1. Vi khuẩn Bacillus là gì?
Bacillus là nhóm vi khuẩn Gram dương, dạng trực khuẩn, có khả năng tạo bào tử – cấu trúc giúp vi khuẩn tồn tại lâu dài trong điều kiện khắc nghiệt. Bacillus phân bố rộng trong đất, nước, trầm tích ao nuôi và cả trong đường ruột động vật.
Đặc điểm nổi bật của Bacillus:
- Tạo bào tử bền vững khi gặp môi trường bất lợi.
- Kích hoạt nhanh khi gặp điều kiện lý tưởng, tăng sinh mạnh.
- Sản sinh enzyme sinh học giúp phân giải chất hữu cơ.
- Tiết kháng sinh tự nhiên, ức chế vi khuẩn gây bệnh.
- Tồn tại được trong pH rộng, nhiệt độ dao động và môi trường giàu hữu cơ.
Nhờ những đặc tính này, Bacillus được xem là vi khuẩn nền tảng trong công nghệ sản xuất chế phẩm sinh học nông nghiệp.
2. Vì sao vi khuẩn Bacillus có khả năng thích nghi cao trong nông nghiệp?
Khả năng thích nghi vượt trội của Bacillus xuất phát từ ba nhóm yếu tố quan trọng:
Hình thái học đặc biệt – tạo bào tử
Bacillus có khả năng:
- Chịu nhiệt độ cao.
- Chịu pH bất lợi.
- Thích nghi độ mặn và điều kiện khan dinh dưỡng.
Bào tử cho phép Bacillus tồn tại trong quá trình vận chuyển, bảo quản và kích hoạt mạnh khi sử dụng trong ao nuôi – đất trồng – chuồng trại.
Phân bố tự nhiên rộng
Bacillus có mặt ở hầu hết các hệ sinh thái:
- Đất nông nghiệp.
- Ao nuôi thủy sản, nước ngọt – lợ – mặn.
- Đường ruột động vật và thủy sản.
Điều này chứng minh Bacillus đã thích nghi sinh học hoàn chỉnh với mọi môi trường liên quan đến nông nghiệp.
Đặc tính sinh hóa vượt trội
Bacillus là “nhà máy enzyme” tự nhiên:
- Sinh protease, amylase, cellulase, lipase.
- Phân giải nhanh hữu cơ, thức ăn thừa, xác bã.
- Ức chế Vibrio, Aeromonas, nấm hại rễ, vi sinh vật gây bệnh đường ruột.
- Hoạt động ổn định khi pH – độ mặn – nhiệt độ biến động.
Chính sự bền vững này giúp Bacillus trở thành nhóm vi sinh được ứng dụng rộng rãi nhất trong nông nghiệp sinh học hiện nay.

3. Ứng dụng của vi khuẩn Bacillus trong nông nghiệp
Ứng dụng trong thủy sản
Bacillus được xem là “xương sống” của chế phẩm vi sinh ao nuôi, với những vai trò chính:
- Làm sạch môi trường nước: phân hủy bùn đáy, thức ăn thừa, giảm NH3, NO2, H2S.
- Ổn định pH – màu nước – hệ vi sinh đáy ao.
- Tăng cường tiêu hóa – miễn dịch cho tôm cá.
- Ức chế Vibrio, hạn chế bệnh gan tụy, phân trắng, đục cơ.
Nhờ đó, Bacillus giúp giảm sử dụng kháng sinh, tăng tỷ lệ sống và hiệu quả kinh tế cho người nuôi.
Ứng dụng trong trồng trọt
Trong lĩnh vực trồng trọt, Bacillus đóng vai trò cải tạo đất và bảo vệ rễ:
- Phân giải xác bã hữu cơ, cải thiện cấu trúc đất.
- Hòa tan lân khó tan, tăng hấp thu N–P–K.
- Hạn chế nấm bệnh hại rễ.
- Kích thích bộ rễ phát triển mạnh, tăng sức đề kháng.
Bacillus đang được ứng dụng rộng rãi trên cây ăn trái, rau màu, cây công nghiệp và lúa.
Ứng dụng trong thú y
Bacillus được sử dụng như probiotic đường ruột:
- Ổn định hệ vi sinh đường ruột.
- Giảm tiêu chảy, tăng hấp thu thức ăn.
- Tăng miễn dịch tự nhiên.
- Giảm mùi hôi chuồng trại.
Đây là hướng đi quan trọng trong mô hình chăn nuôi an toàn sinh học, giảm kháng sinh.

4. Lựa chọn chủng Bacillus chuẩn – yếu tố quyết định hiệu quả sản phẩm
Hiệu quả thực tế không chỉ phụ thuộc vào chi Bacillus mà phụ thuộc mạnh vào:
- Chủng Bacillus cụ thể.
- Độ thuần và hoạt lực.
- Tính ổn định trong sản xuất công nghiệp.
Đây là lý do Bio-Floc tập trung cung cấp chủng Bacillus thuần mã hóa như: Bacillus licheniformis Ba60, Bacillus amyloliquefaciens KP3, Bacillus subtilis Ba02, Bacillus subtilis Ba02, Bacillus clausii Ba05, được phân lập – tuyển chọn – kiểm soát nghiêm ngặt, đảm bảo hoạt tính sinh học và độ ổn định cao.
Với bộ chủng Bacillus thuần mã hóa, Bio-Floc đồng hành cùng các doanh nghiệp sản xuất chế phẩm vi sinh, giúp:
- Tối ưu hiệu quả sản phẩm.
- Ổn định chất lượng.
- Phát triển thương hiệu bền vững.
Hãy liên hệ ngay với Bio-Floc – nhà máy nghiên cứu và sản xuất nguyên liệu vi sinh đạt tiêu chuẩn Quốc tế ISO 9001:2015 để được tư vấn chi tiết.

